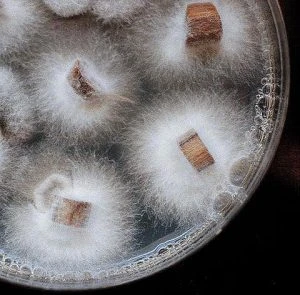
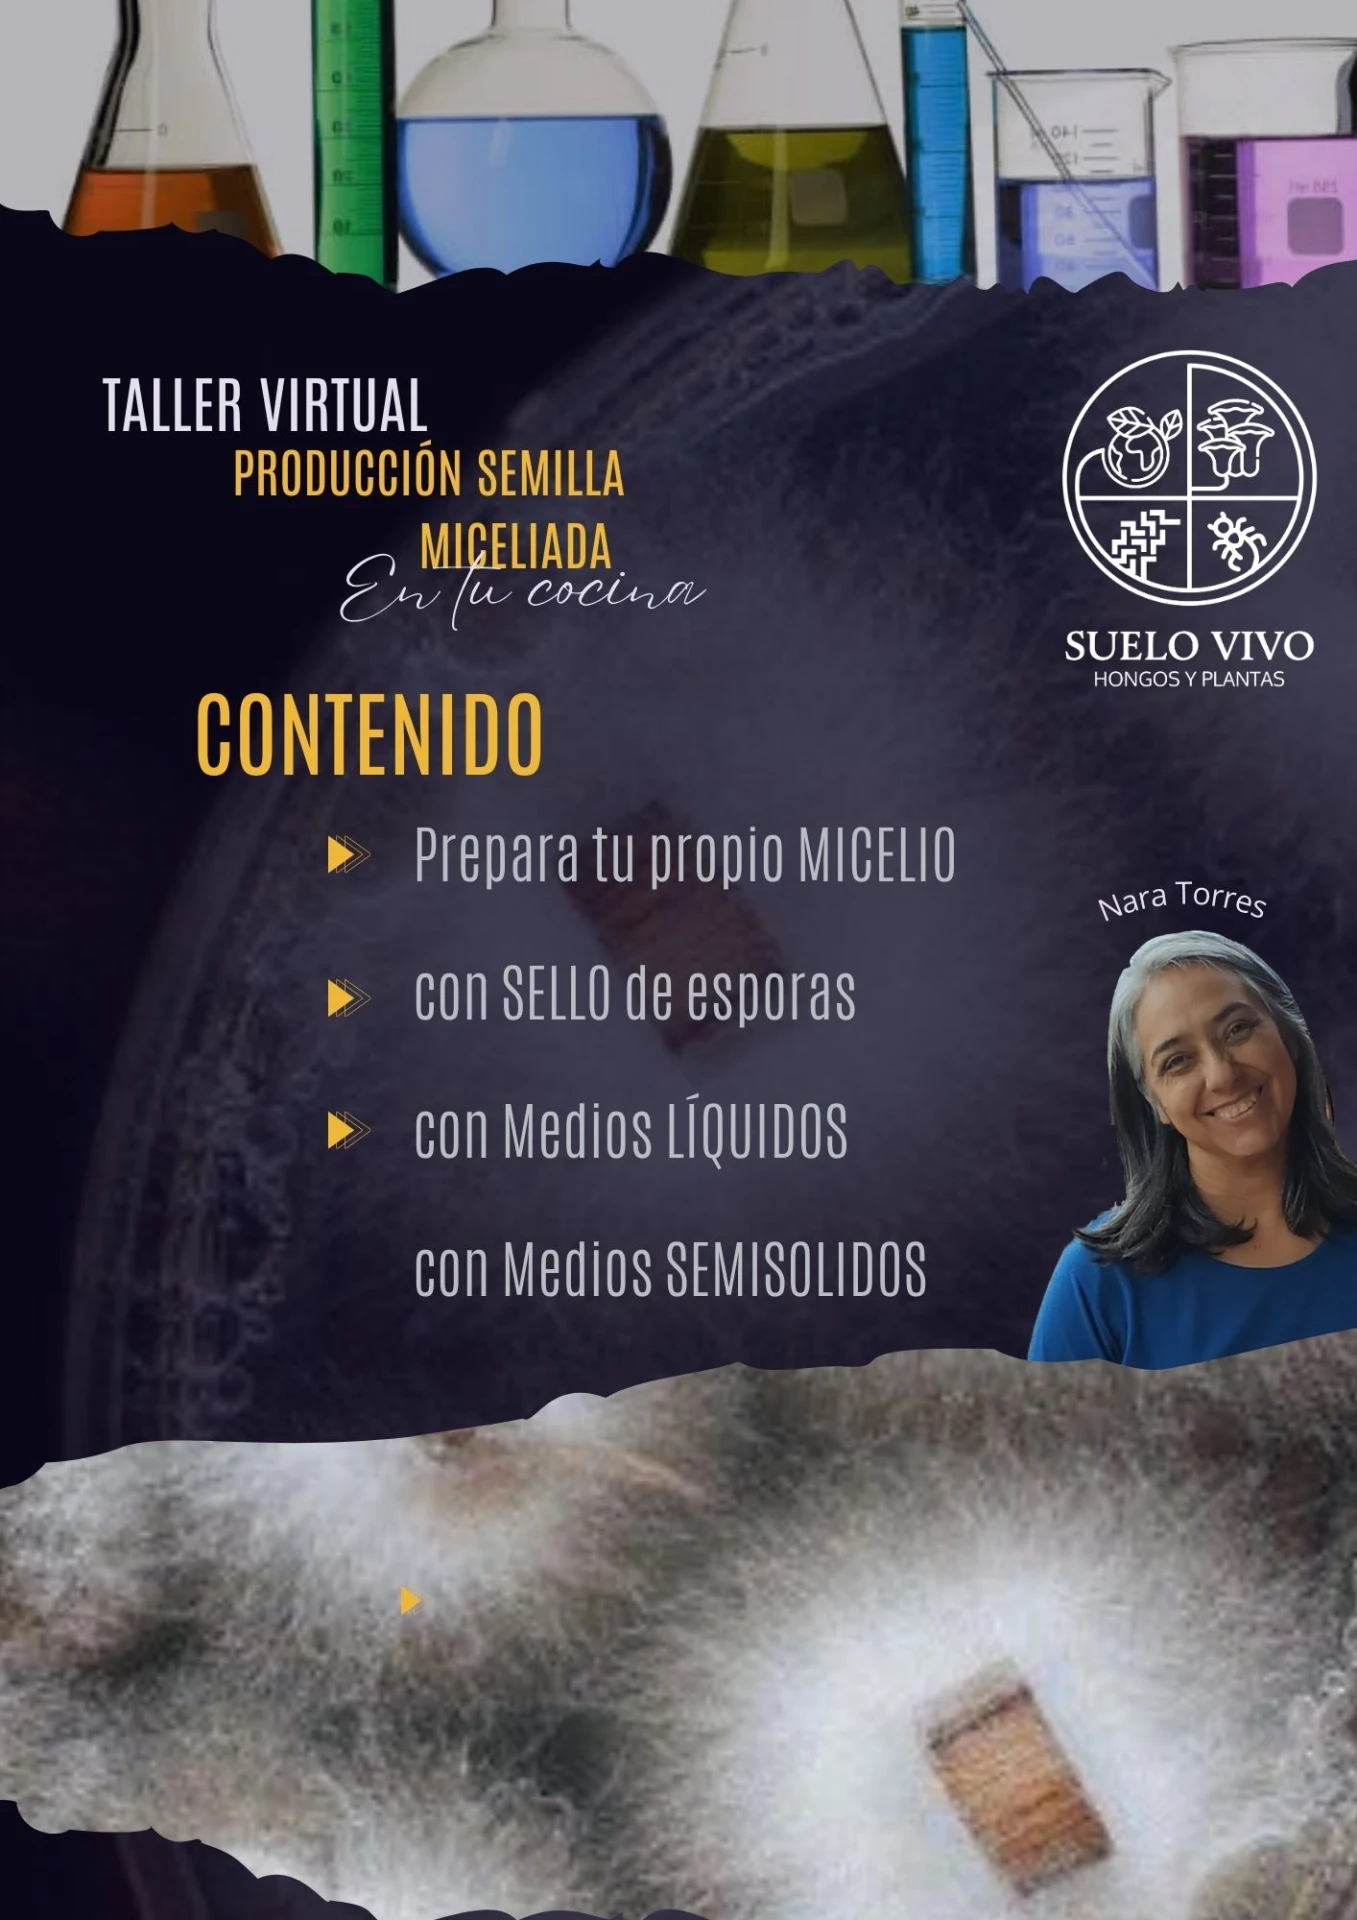

Descripción
PROXIMAMENTE! ATENCION a la preventa, vouchers para suscriptores del EMAILMARKETING.
Este curso está diseñado para guiarte en todos los aspectos necesarios para producir semillas miceliadas de hongos superiores desde la comodidad de tu hogar. Ideal para fungicultores tanto principiantes como avanzados, aprenderás a cultivar tus propios hongos comestibles y medicinales con técnicas fáciles y prácticas.
En Este Curso Verás:
- Videos Teóricos y Prácticos: Detallados, explicando cada técnica y su propósito.
- Medios de Cultivo: Aprende sobre los medios de cultivo enriquecedor, selectivo y diferencial.
- Ciclo de Vida de los Hongos: Conoce el ciclo de vida de hongos superiores.
- Técnicas de Propagación: Métodos para la producción de semilla miceliada, incluyendo la técnica "Grain to Grain" (G2G).
- Obtención y Manejo de Cepas: Cómo conseguir y manejar cepas de laboratorio y cómo enfrentar contaminaciones.
- Preparación de Medios de Cultivo Líquidos y Semisólidos: Procedimientos detallados.
- Esterilización y Zona de Trabajo: Cómo preparar tu cocina para trabajar con esterilidad.
- Control de Temperatura e Incubación: Recursos y sugerencias para mantener los parámetros adecuados.
Beneficios del Curso:
- Acceso de por Vida: Compra una vez y accede a los videos para siempre, incluyendo actualizaciones y nuevo material.
- Asesorías Grupales: Participa en clases de asesoría grupal mensual para revisión de técnicas y eliminación de dudas.
- Consultoría Extendida: Dos sesiones adicionales de consultoría dentro del primer cuatrimestre.
- Grupos de Intercambio: Únete a los grupos cerrados de WhatsApp y Facebook para interactuar con otros alumnos y compartir experiencias.
Bonus:
- Videos Adicionales y Materiales Descargables: Acceso a videos bonus y PDFs con protocolos de procedimientos.
- Canal de Nara Torres en YouTube: Clases adicionales gratuitas sobre temas afines a los reinos Flora y Funga.
- Instagram de Suelo Vivo: Curiosidades y experiencias sobre hongos y plantas adaptógenas.
Formato del Curso:
- Videos Asincrónicos: Acceso exclusivo a una playlist “no listada” de YouTube para los alumnos.
- Consultoría Grupal: Reuniones por Google Meet para resolver dudas y revisar técnicas.
- Material PDF: Guías y protocolos de procedimientos descargables.
- Grupo de Facebook: Espacio para compartir trabajos, compras, proveedores, aciertos y errores entre alumnos.